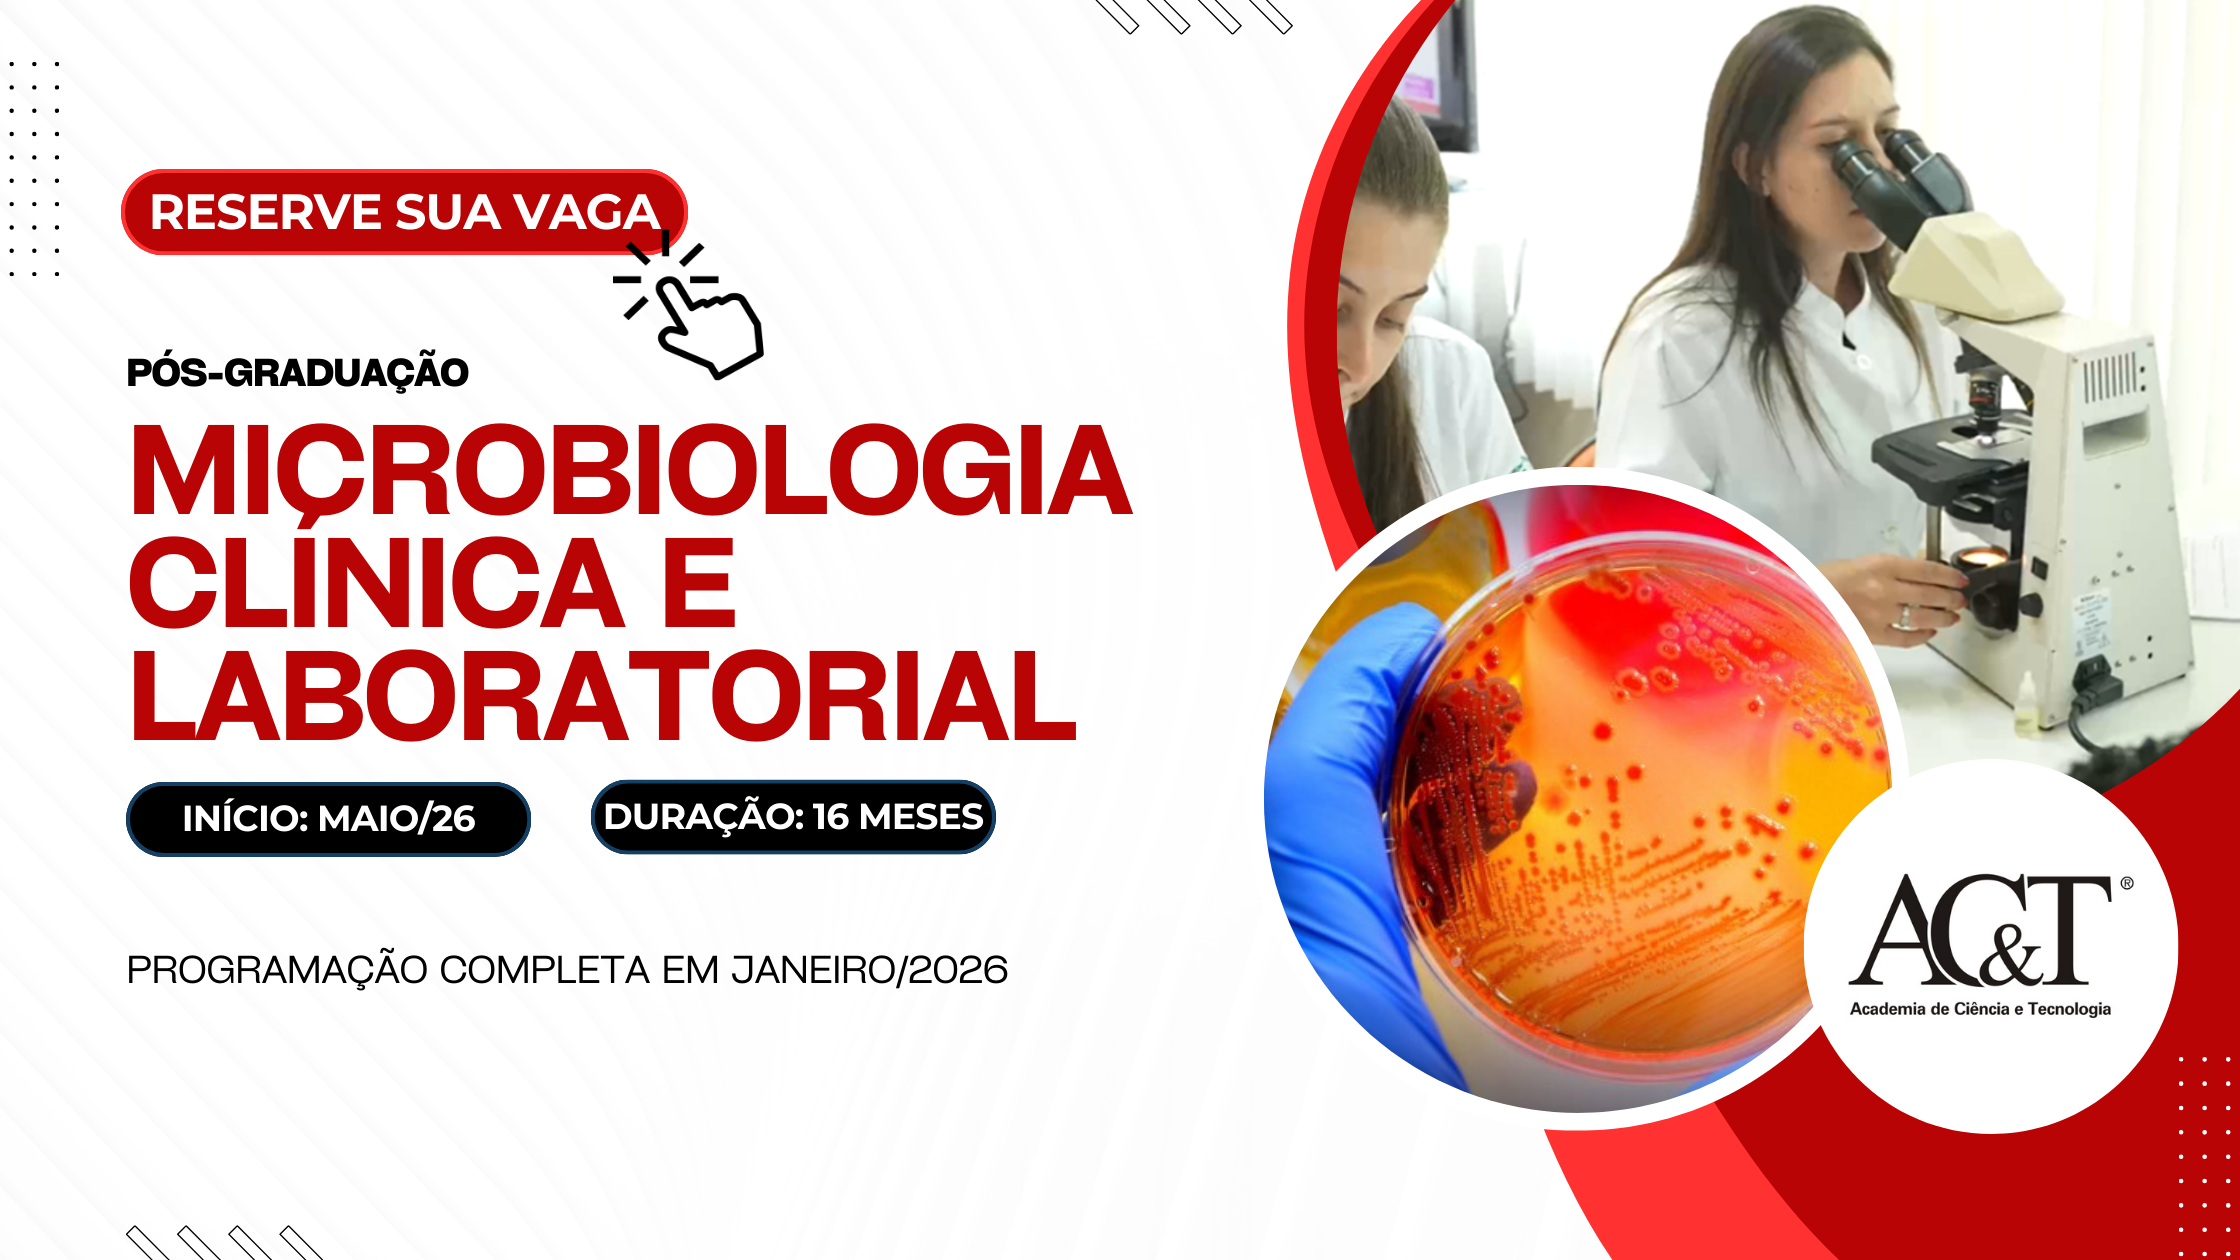
Pós-graduação em Microbiologia Clínica e Laboratorial - 2026 - aulas práticas.

Especialize-se com quem é referência nacional e desenvolva competências reais para atuar com segurança em laboratórios de análises clínicas.
PÓS-GRADUAÇÃO E OUTROS CURSOS
Pós em Microbiologia Clínica e Laboratorial
Início em Maio de 2026.
Especialização em Microbiologia com 16 meses de formação, com encontros presenciais bimestrais, unindo teoria sólida, discussão de casos e aulas práticas em laboratórios próprios. Com mais de 20 anos de tradição, corpo docente de excelência e acomodação gratuita nos encontros presenciais, o curso é ideal para profissionais que buscam segurança e destaque na bancada, juntamente com diferenciação real no mercado.
Pós em Hematologia Clínica e Laboratorial
Início em Setembro de 2026.
Torne-se uma referência em hematologia laboratorial em 17 meses, com encontros presenciais bimestrais. A especialização em hematologia oferece formação sólida com aulas práticas em laboratórios próprios e discussão de casos reais. Com mais de 25 anos de tradição, corpo docente altamente qualificado e acomodação gratuita nos encontros presenciais, é uma oportunidade única para quem busca excelência nas análises hematológicas.
POR QUÊ FAZER PÓS-GRADUAÇÃO NA AC&T?
Porque o mercado não busca apenas diplomas — busca profissionais preparados.
Na AC&T, você desenvolve competência prática real em áreas essenciais como hematologia e microbiologia, com formação presencial e contato direto com o professor e com a rotina laboratorial.
✔ Mais de 25 anos formando especialistas reconhecidos
✔ Formação valorizada por laboratórios, empregadores e universidades
✔ Certificado de Pós presencial aceito automaticamente pelos conselhos de classe
✔ Ensino focado no que o mercado realmente exige
Somos a única instituição a oferecer acomodação gratuita nos encontros presenciais.
👉 Aqui, você não apenas estuda — você se prepara para crescer na carreira e tornar-se referência na sua área de atuação.
EVENTOS
Confira a participação do Dr Flávio Naoum, diretor da AC&T, no 57º Congresso Brasileiro de Patologia Clínica da SBPC/ML
Rio de Janeiro, de 16 a 19 de setembro de 2025
Nos últimos anos, o Prof Dr Flávio Naoum tem representado a AC&T no maior Congresso de Hematologia do Brasil, o HEMO
MATERIAIS DE LIVRE ACESSO
EM 20 ANOS DE AC&T OFERECEMOS:
63 CURSOS DE PÓS | 3043 ALUNOS | 550 CIDADES | 24 ESTADOS DO BRASIL, PARAGUAI E COLÔMBIA
VENHA FAZER PARTE DESTA HISTÓRIA
AC&T: OS NÚMEROS SÃO RELEVANTES
VEJA NOSSOS VÍDEOS: 5 MILHÕES DE ACESSOS